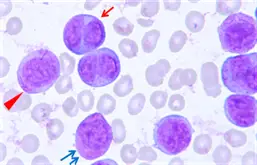
圖片

110年:(醫檢)血液(1)
單箭頭所指的細胞呈現 dumbbell 的細胞核型態,實心三角所指的是細胞內棒狀物;雙箭頭所指的細胞,細胞質充滿顆粒。這些細胞最常出現在下列何種疾病?
AAcute promyelocytic leukemia
BAcute lymphoblastic leukemia
CBurkitt lymphoma/leukemia
DMyelodysplastic syndrome
詳細解析
本題觀念:
本題考查急性前骨髓細胞白血病 (Acute Promyelocytic Leukemia, APL) 的典型細胞形態學特徵。醫檢師需具備辨識異常前骨髓細胞 (Abnormal promyelocytes) 的能力,因為 APL 經常伴隨嚴重出血風險 (DIC),是血液科急症,需即時通報。
影像與形態描述分析:
題目描述了三個關鍵的形態學特徵,這些都是 APL 的經典表現:
-
單箭頭 (Dumbbell 細胞核型態):
- 分析:細胞核呈現啞鈴狀 (dumbbell-shaped) 或雙葉狀 (bilobed),這在血液型態學上常被稱為 "Buttock cell" (屁股細胞) 或 "Butterfly" (蝴蝶狀)。
- 臨床意義:這是 APL 異常前骨髓細胞的特徵性核型,特別常見於微顆粒型 APL (Microgranular variant, M3v),但在典型 APL 中亦可見到核摺疊或分葉。
-
實心三角 (細胞內棒狀物):
- 分析:指的就是 Auer rod (奧爾氏體)。
- 臨床意義:Auer rod 是由初級顆粒 (primary granules) 融合而成的針狀物,僅見於骨髓性白血
...(解析預覽)...

升級 VIP 解鎖圖文解析